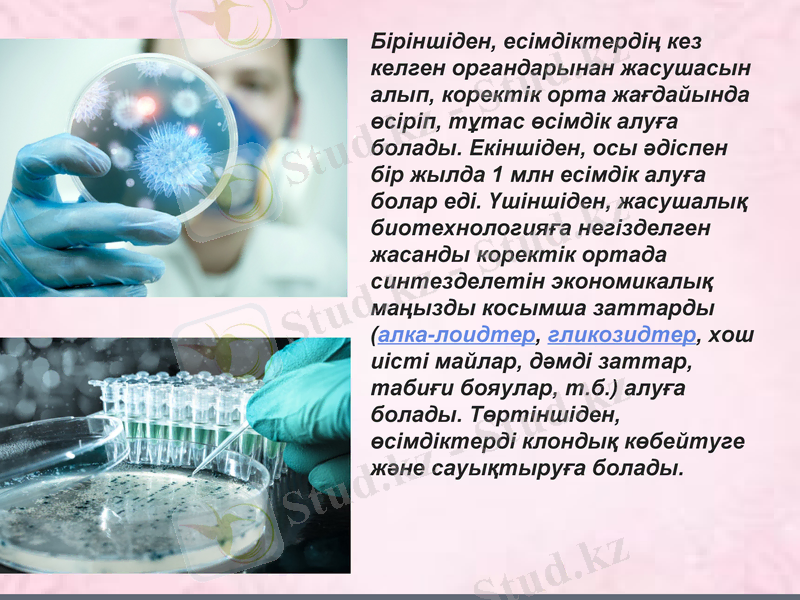
Slide 9

Биотехнология: XXI ғасырдың ғылымы мен негізгі бағыттары




Биотехнология дегеніміз
Биотехнология бағыттары
Гендік инженерия
Жасушалық инженерия
Медициналық биотехнология
Қорытынды
Жоспар:

Биотехнология дегеніміз - биологиялық организмдердің қатысуымен жүретін процестерді, адамның мақсатына сай өзгерту арқылы өндірісте пайдалану. "Биотехнология" деген терминді алғаш рет 1919 жылы венгр ғалымы К. Эреки енгізді. Қазіргі биотехнологияның басты мақсаты - өсімдіктердің жаңа сорттарын, жануарлардың асыл тұкымын, микроорганизмдердің штаммаларын шығару. Оны адам өміріне қажетті заттар өндіру үшін биологиялық нысандар мен процестерге негізделген жаңа ғылымның және өндірістің сапасы деп қарауға болады. Ата-әжелеріміз ежелден микроорганизмдерді қымыз бен шұбат, айран ашытуға, құрт пен ірімшік жасауға, нан пісіруге, тері илеуге, т. б. қажетті заттарды дайындауға пайдаланған. Қазіргі биотехнологияның мынадай негізгі бағыттары бар: микробиологиялық өндіріс, жасушалықинженерия жөне гендік инженерия.



.

Жасушалық инженерия
Жасушалық инженерия - дене жасушаларына будандастыру әдiсiн қолдана басталуымен немесе екi әртүрлi жасушалардың ұлпа себiндiсiнде қосылуынан пайда болды. Ол үшiн жасуша жарғағын бiраз бұзады. Бұрын мұндай бүлiнудi Сендая вирусы тудыратын, қазiр оны химиялық заттар әсерi бередi. Сондықтан организм жасушаларының әр, тiптi алыс түрлерi қосыла алады. Мұндай жасуша - гетерокарион жасушалары деп аталады.

.
Біріншіден, есімдіктердің кез келген органдарынан жасушасын алып, коректік орта жағдайында өсіріп, тұтас өсімдік алуға болады. Екіншіден, осы әдіспен бір жылда 1 млн есімдік алуға болар еді. Үшіншіден, жасушалық биотехнологияға негізделген жасанды коректік ортада синтезделетін экономикалық маңызды косымша заттарды (алка-лоидтер, гликозидтер, хош иісті майлар, дәмді заттар, табиғи бояулар, т. б. ) алуға болады. Төртіншіден, өсімдіктерді клондық көбейтуге және сауықтыруға болады.

Микроорганизмдерге сыртқы ортаның факторларының әсері.
Табиғатта микроорганизмдерге абиотикалық факторлармен қатар олармен бірге тіршілік ететін организмдер, биотикалық факторлар да әсер етеді.

Медицинадағы биотехнология
Бұл адамның диагностикасында емдеуіне және де профилактасын тіру организм қолдану арқылы емдеу


Қорытынды
Биотехнология 21 ғасыр мамандығы екенін жоғарыда дәлелдеп кеттім. Тірі организмдердің көмегімен адамзат және қоршаған ортаны қорғай аламыз деп айта аламын. Биотехнология жаңа эксперименттер мен жобалардын есігін аша білетін мамандық. Ол нанотехнологиялардың барлығын қолдана отырып, қаркынды дамимыз деп толықтай айта аламын

- Іс жүргізу
- Автоматтандыру, Техника
- Алғашқы әскери дайындық
- Астрономия
- Ауыл шаруашылығы
- Банк ісі
- Бизнесті бағалау
- Биология
- Бухгалтерлік іс
- Валеология
- Ветеринария
- География
- Геология, Геофизика, Геодезия
- Дін
- Ет, сүт, шарап өнімдері
- Жалпы тарих
- Жер кадастрі, Жылжымайтын мүлік
- Журналистика
- Информатика
- Кеден ісі
- Маркетинг
- Математика, Геометрия
- Медицина
- Мемлекеттік басқару
- Менеджмент
- Мұнай, Газ
- Мұрағат ісі
- Мәдениеттану
- ОБЖ (Основы безопасности жизнедеятельности)
- Педагогика
- Полиграфия
- Психология
- Салық
- Саясаттану
- Сақтандыру
- Сертификаттау, стандарттау
- Социология, Демография
- Спорт
- Статистика
- Тілтану, Филология
- Тарихи тұлғалар
- Тау-кен ісі
- Транспорт
- Туризм
- Физика
- Философия
- Халықаралық қатынастар
- Химия
- Экология, Қоршаған ортаны қорғау
- Экономика
- Экономикалық география
- Электротехника
- Қазақстан тарихы
- Қаржы
- Құрылыс
- Құқық, Криминалистика
- Әдебиет
- Өнер, музыка
- Өнеркәсіп, Өндіріс
Қазақ тілінде жазылған рефераттар, курстық жұмыстар, дипломдық жұмыстар бойынша біздің қор #1 болып табылады.



Ақпарат
Қосымша
Email: info@stud.kz